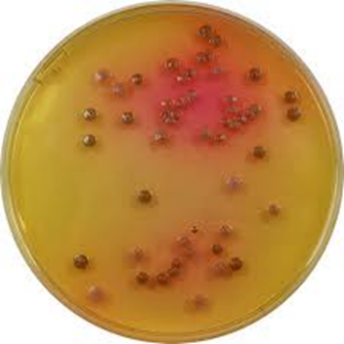

Uz uyatsiz rasimlar pornolar - omlar sekis, hayvonlar bilan zapallar
Uz omlar galereyalar, qizlar xxx zorlash. Смазливые Узбекские девушки с радостью попробуют на вкус сперму, причём даже не одного, а нескольких удовлетворённых Кавказских кавалеров. Sekisler iran узбек секслар, azeri seksleri bax ruski sekisler.Узбекча секис топ
https://uzbek-seks.me
https://pornopopa.net/molodye_devushki/
https://sexuzbek.ru/top/
Топовая русская порнуха
Секс голая узбекча
https://adultsextoysmy.com

Katta kokraklar xxx |

Yalangoch musulmon ayollar fetish |
|---|---|

Sperma yuzida |

Buzuq xotinlar erotikasi |